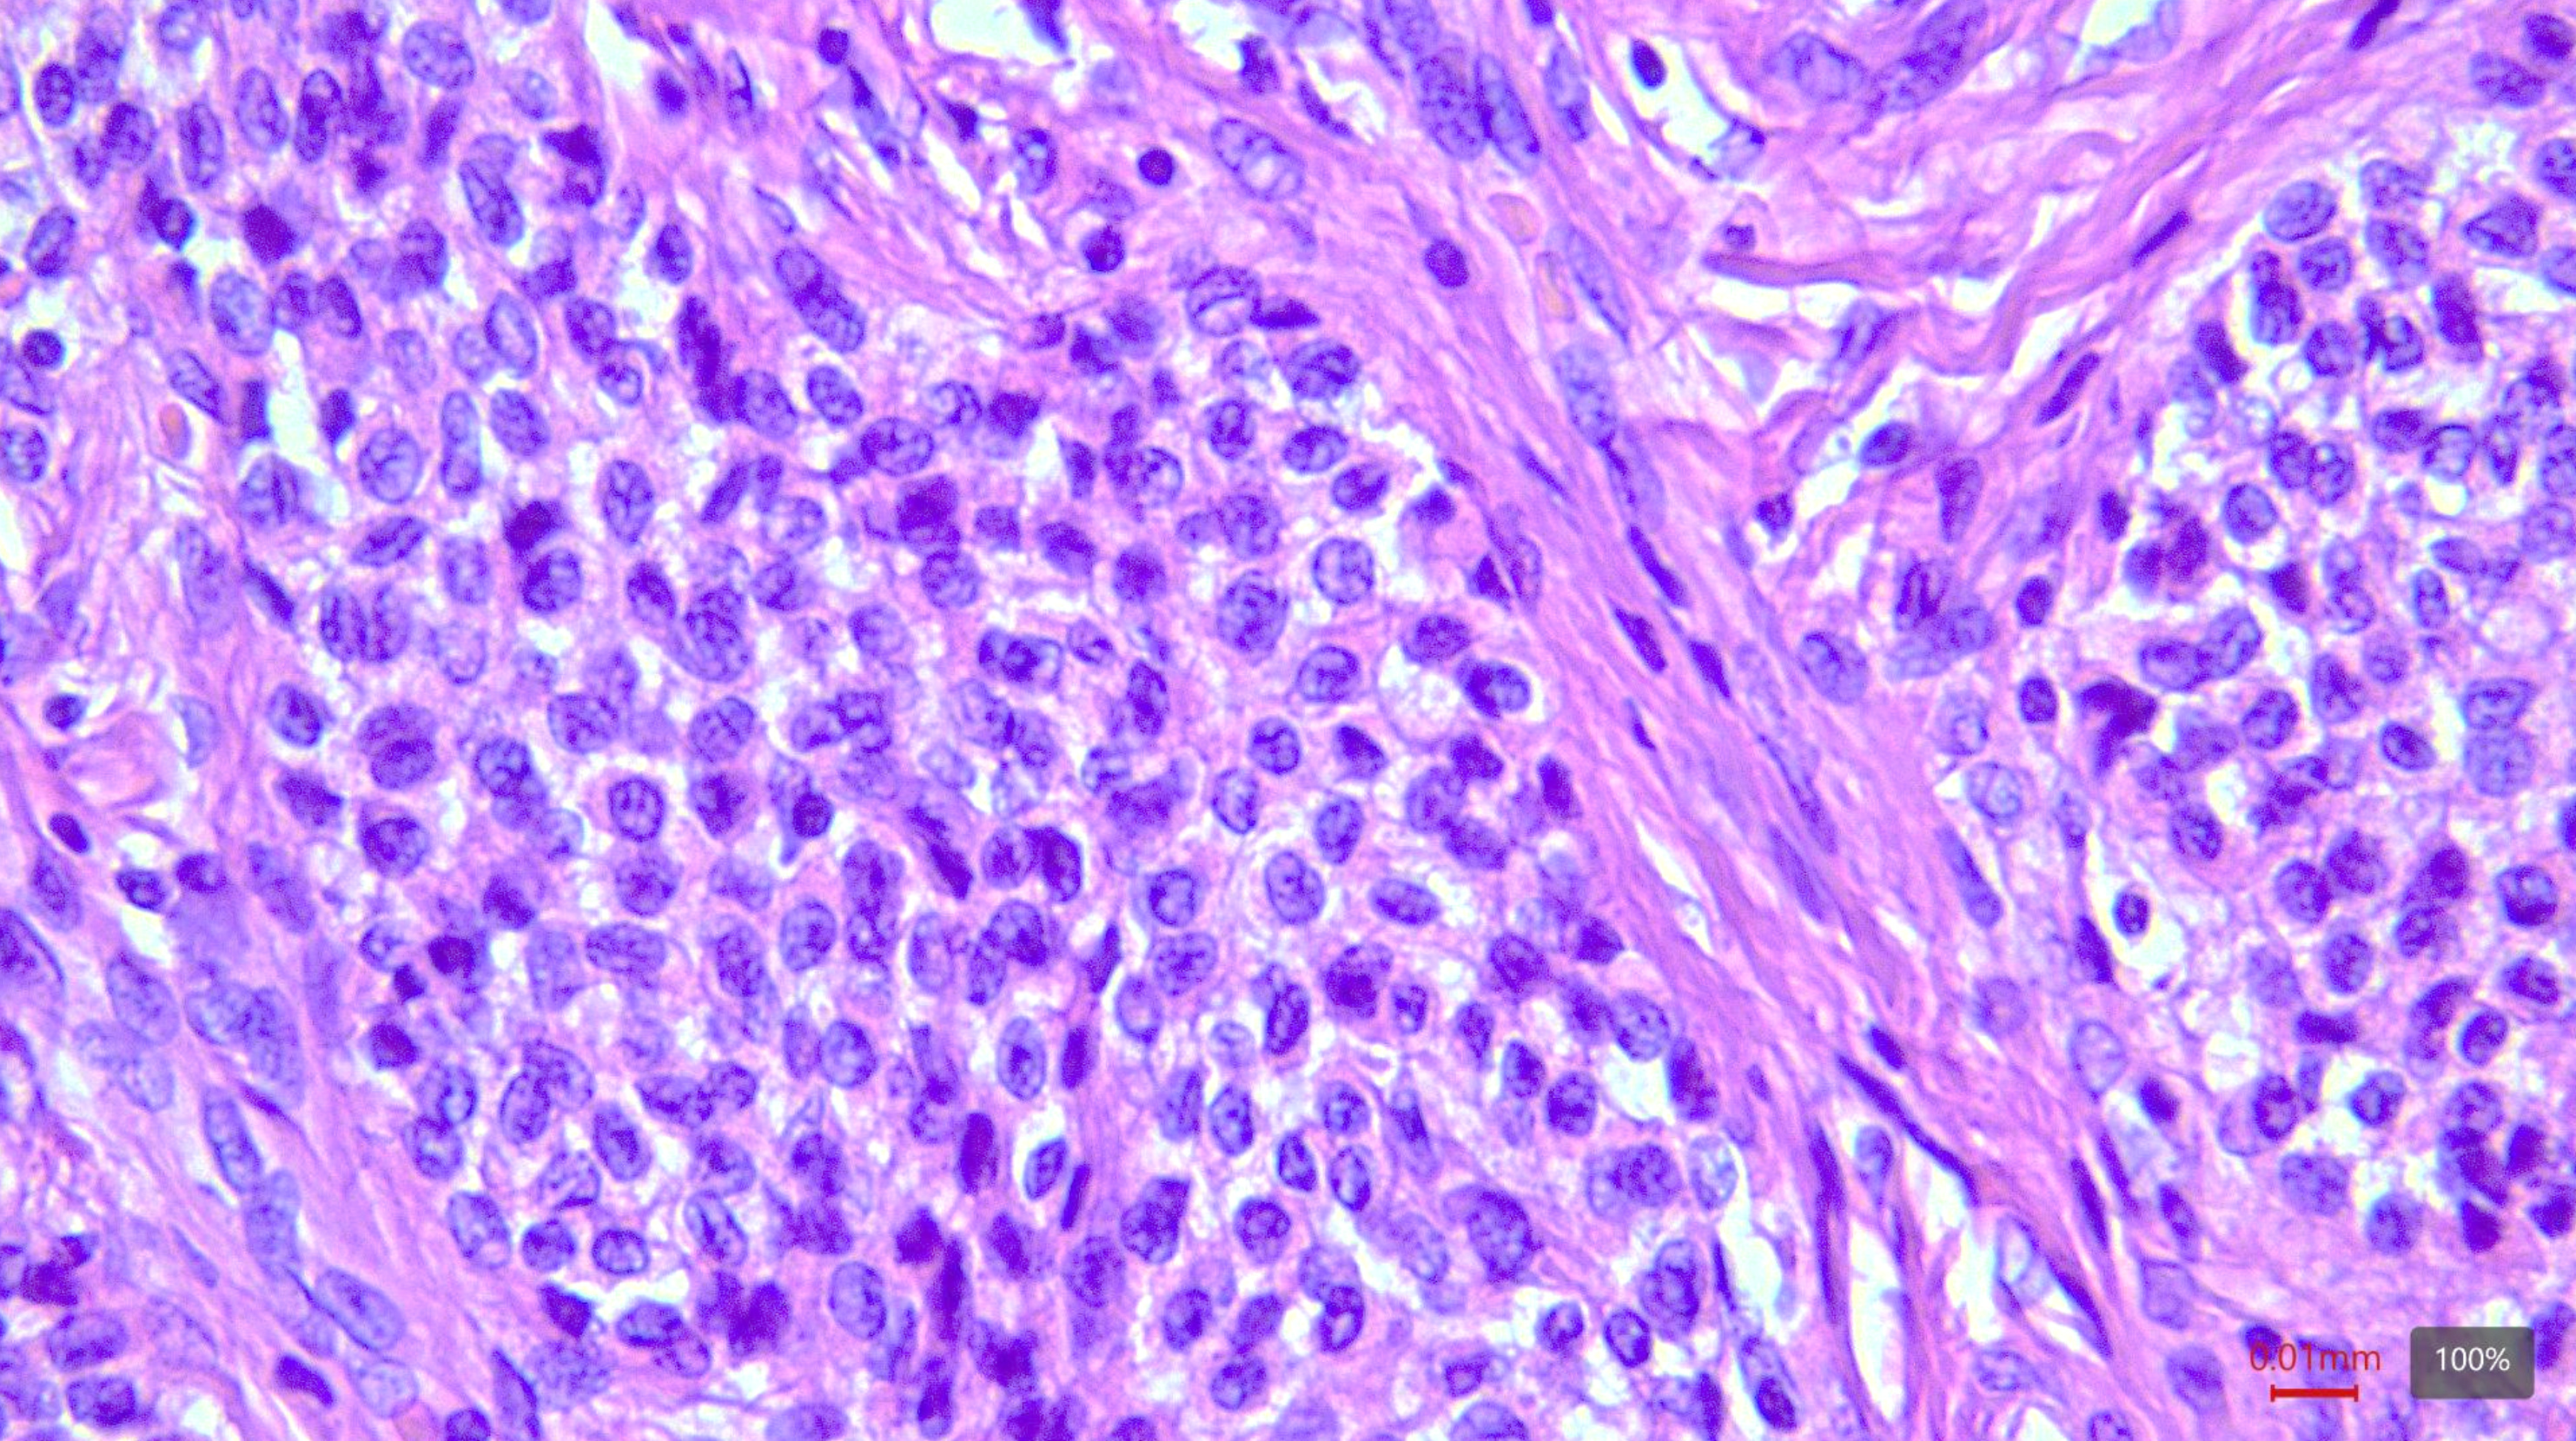
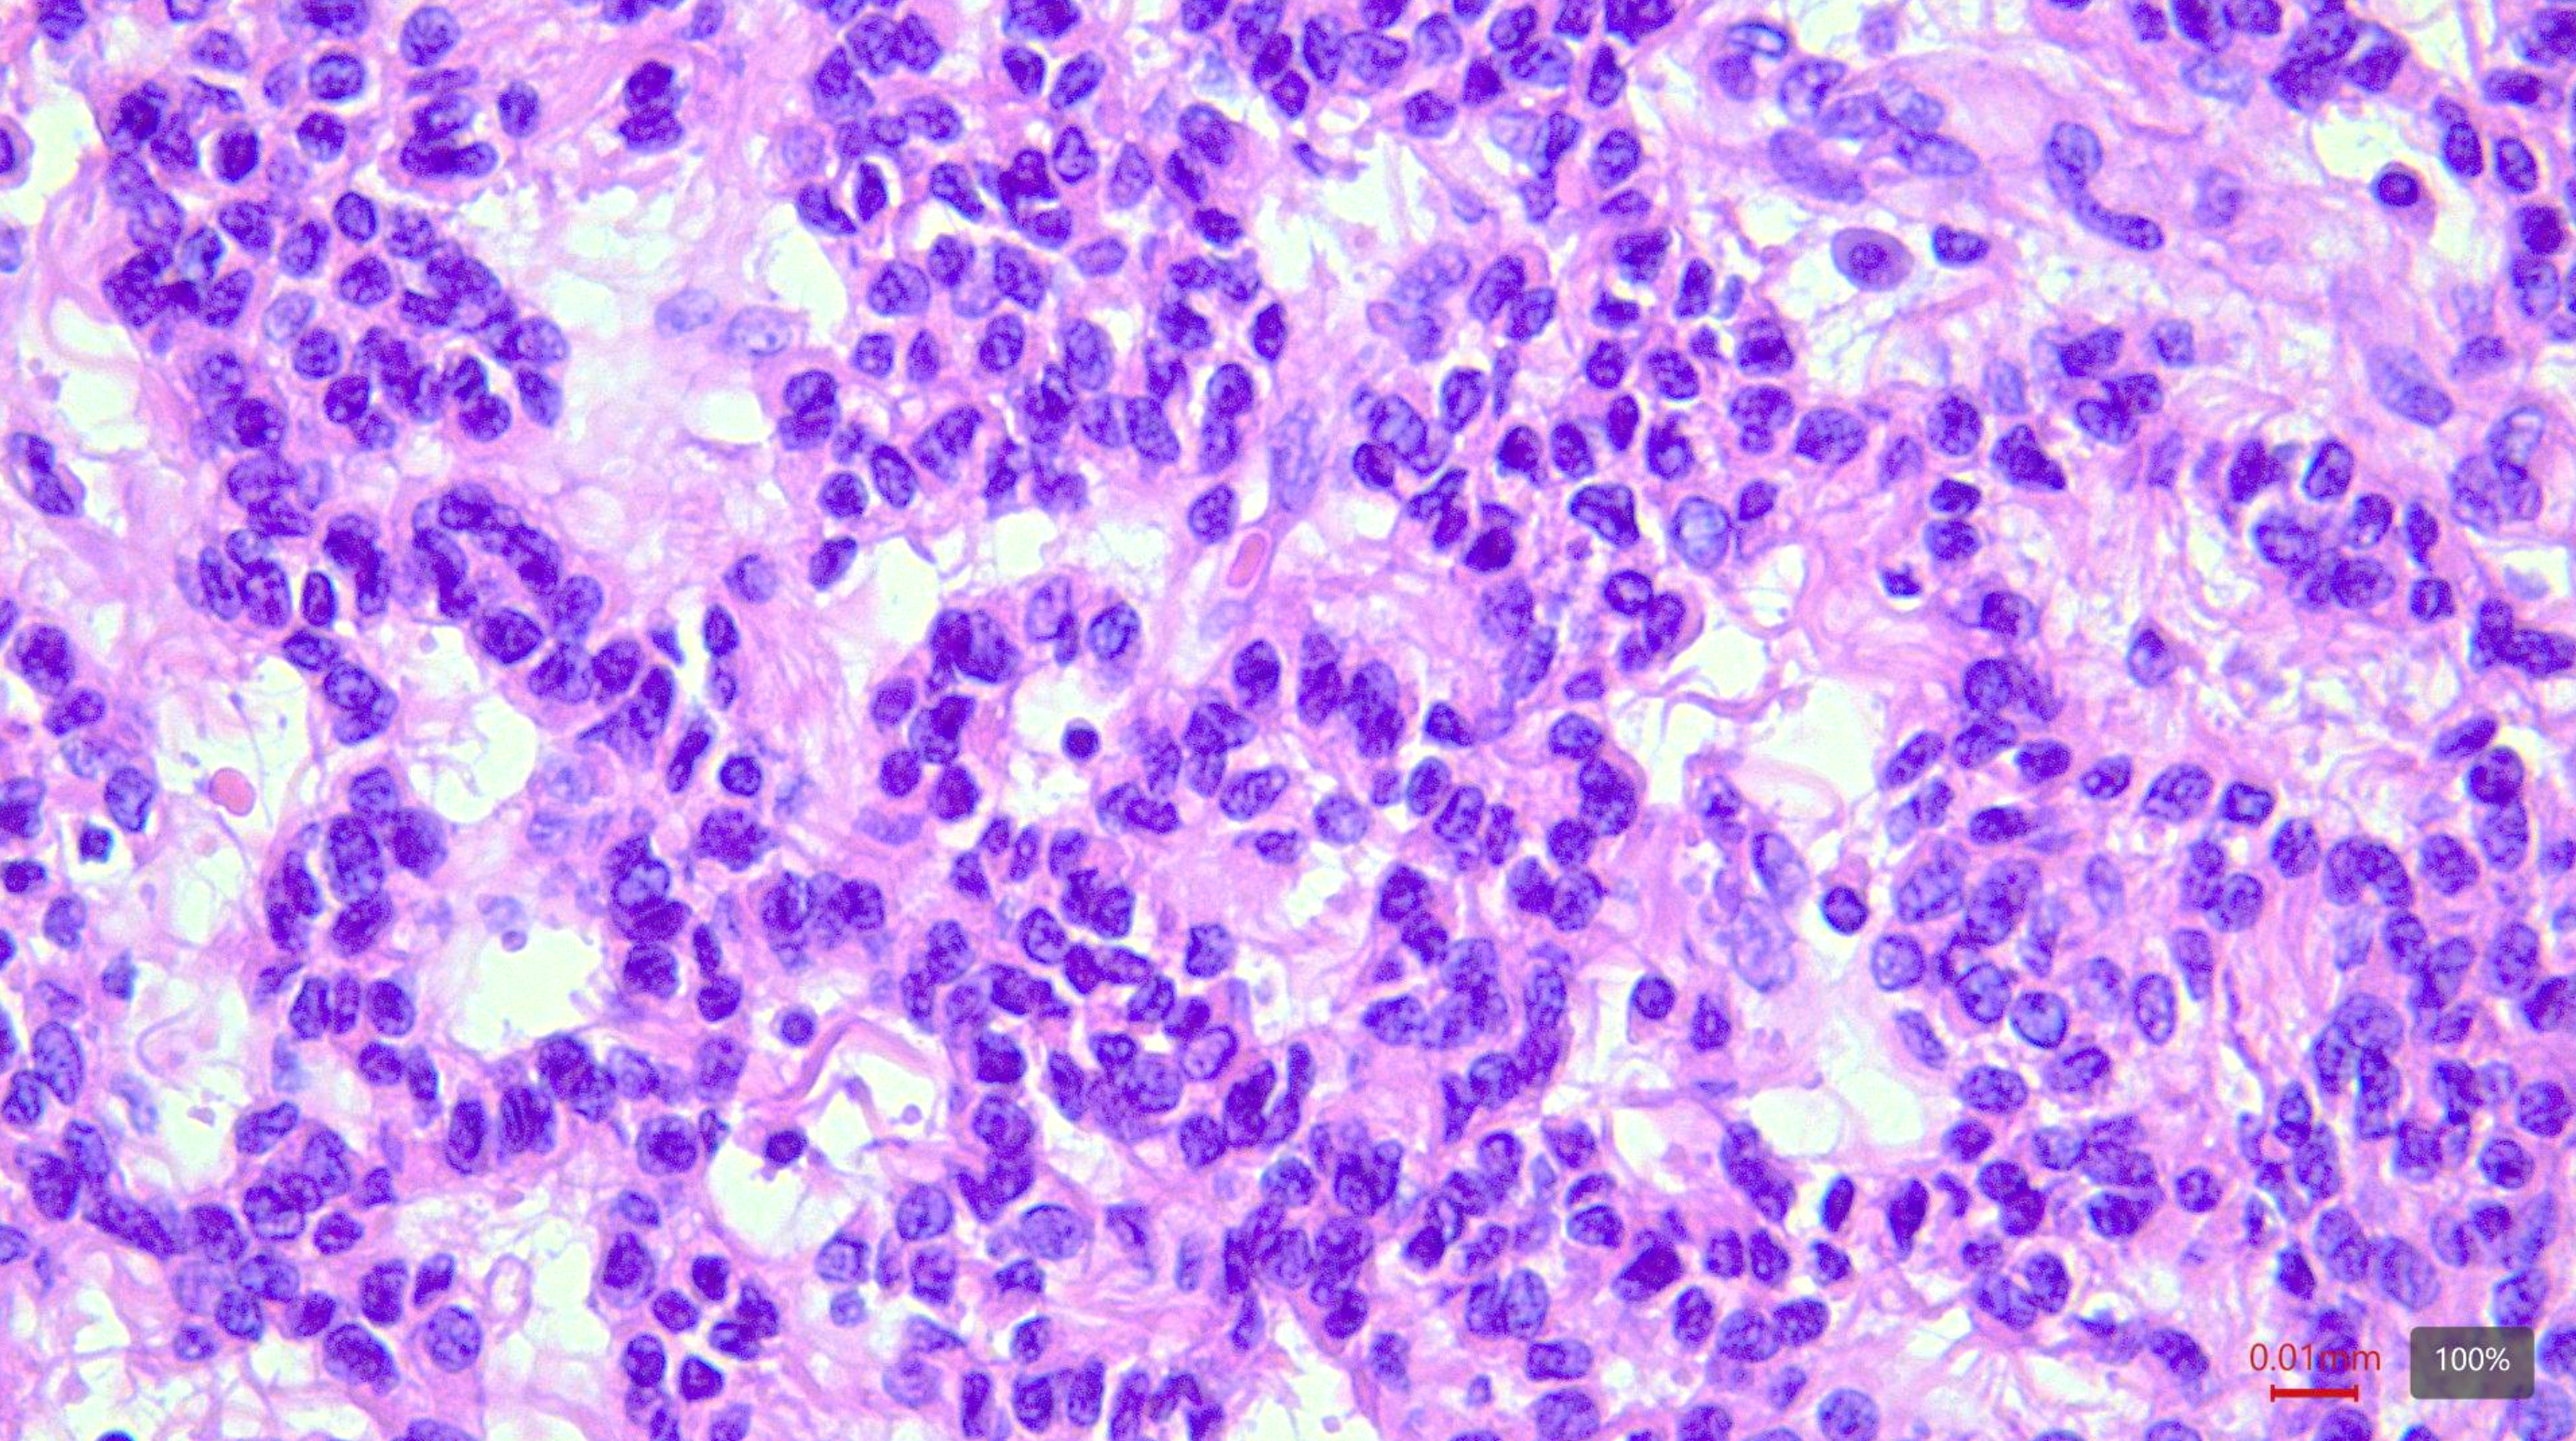

Mujer de 61 años con antecedente de Linfoma difuso de células B grandes.
Se realiza PET/ CT de control en el cual se identifica una lesión con hipermetabolismo en cavidad pélvica de 35 x 45 mm.

1. Mencione el diagnóstico más probable:
a) Sarcoma del estroma endometrial.
b) Tumor uterino similar al tumor del cordón sexual ovárico.
c) Pecoma
d) Leiomioma epidelioide.
2. Mencione los patrones de crecimiento que puede presentar esta neoplasia:
a) Sólido, nidos, cordones y trabéculas.
b) Haces cortos y largos, túbulos y cordones.
c) Sólido y glandular.
d) Glandular y trabecular.
3. ¿Cuál es el perfil de inmunohistoquímica positivo esperado en esta neoplasia:
a) CD10, RE, RP, WT1, Cilina D1.
b) Actina, H-caldesmon, Desmina.
c) CK, Actina, Calretinina, Inhibina.
d) HMB45, Catepsina K, Actina, Desmina, TFE3.